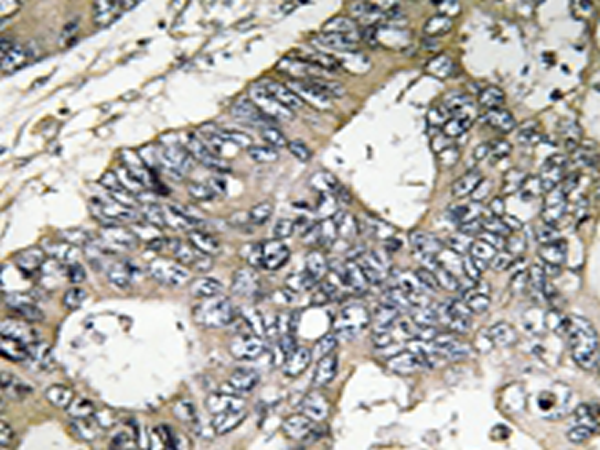

中文名稱:兔抗GUF1多克隆抗體
英文名稱: Anti-GUF1 rabbit polyclonal antibody
別 名: EF-4
抗 原: GUF1
儲 存: 冷凍(-20℃) 避光
宿 主: Rabbit
相關(guān)類別: 一抗
反應(yīng)種屬: Human Mouse
標(biāo)記物: Unconjugate
克隆類型: rabbit polyclonal
技術(shù)規(guī)格
|
Background: |
This gene encodes a GTPase that triggers back-translocation of the elongating ribosome during mitochondrial protein synthesis. The protein contains a highly conserved C-terminal domain not found in other GTPases that facilitates tRNA binding. The encoded protein is thought to prevent misincorporation of amino acids in stressful, suboptimal conditions. An allelic variant in this gene has been associated with early infantile epileptic encephalopathy-40. Alternative splicing results in multiple transcript variants. |
|
Applications: |
IHC |
|
Name of antibody: |
GUF1 |
|
Immunogen: |
Synthesized peptide derived from internal of human GUF1. |
|
Full name: |
GUF1 homolog, GTPase |
|
Synonyms: |
EF4; EF-4; EIEE40 |
|
SwissProt: |
Q8N442 |
|
IHC positive control: |
Human colon carcinoma tissue |
|
IHC Recommend dilution: |
50-100 |
購物車
幫助
021-54845833/15800441009
